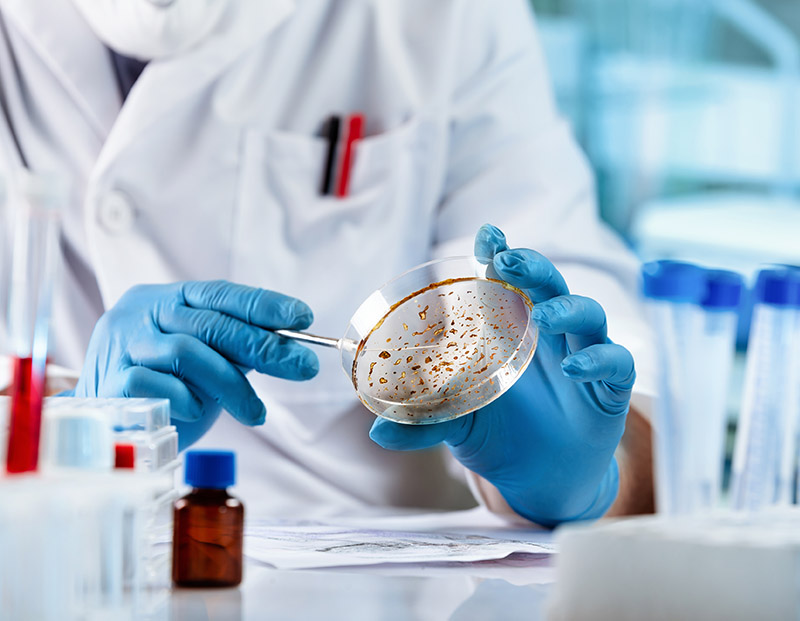

At the heart of Dr. Rao’s practice lies a steadfast dedication to research and innovation. This commitment fuels his expertise and profoundly impacts his patients’ care. By staying at the forefront of medical science, Dr. Rao ensures that his patients benefit from the latest advancements in neurosurgery and spine surgery, leading to more effective treatments, quicker recoveries, and overall better health outcomes.
Dr. Rao’s approach to research and innovation is not merely about advancing his own knowledge. It’s about paving the way for the future of neurosurgery and spine surgery in Australia and beyond. Each project, study, and breakthrough represents a step forward for medical science and a hope for patients. Through his dedication, Dr. Rao is not just practicing medicine but actively shaping its future. His research efforts ensure that his practice remains at the cutting edge of neurosurgical care, offering his patients access to the most advanced treatments available. This combination of hands-on patient care and relentless pursuit of innovation makes Dr. Rao a leader in his field.
Dr. Rao has been part of numerous groundbreaking research projects, including the following:

Dr. Rao has been a trailblazer in the field of Anterior Lumbar Interbody Fusion (ALIF). Through his extensive research culminating in a PhD, he has established why the anterior approach to this procedure is superior to the posterior method. His pioneering work enhances the success rates of surgeries and significantly reduces recovery times for his patients, setting a new standard in spine surgery techniques.
In response to a 2013 study that inaccurately attributed back pain predominantly to bacterial infection, Dr. Rao conducted an exhaustive research study involving 815 patients. His findings successfully debunked the previously held beliefs, providing clarity and reassurance for those suffering from back pain. This study exemplifies Dr. Rao’s commitment to evidence-based practice and dedication to correcting misconceptions in his field.

Recognizing the lack of research on Ehlers-Danlos Syndrome, a condition that profoundly affects young people, Dr. Rao took an unprecedented step by funding his own research into the syndrome. His efforts aim to uncover effective treatment methods that can offer relief and hope to those affected by this condition. This is a testament to his commitment to solving complex medical problems and improving patient care through innovative research.

Discover Dr. Rao’s groundbreaking work in neurosurgery and spine surgery. Dr. Rao is ranked as the 6th most cited researcher in neurosurgery and spine surgery in Australia, with his work cited over 5,000 times (h-index: 34, i10-index: 59).
One of his co-authored articles on lumbar interbody fusion remains among the 10 most cited in spine surgery, and several of his publications have been referenced in patents.
Click below to explore more than 70 publications on cutting-edge topics. Join us in advancing patient-centred care.
Under Dr. Rao’s expert care, patients can expect compassionate, patient-centred care tailored to their unique needs. With a commitment to research and innovation, Dr. Rao ensures each patient benefits from the most advanced care available.